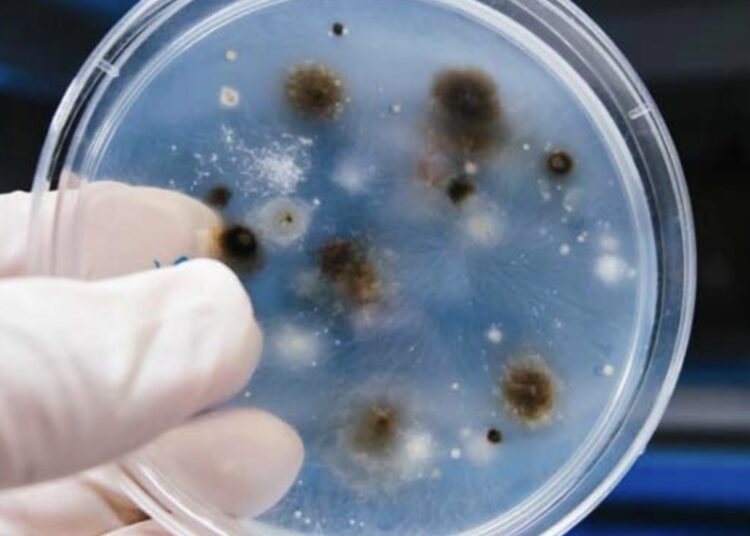
Descubren hongos que comen plástico como si fuera madera

Un grupo de biólogos Sri Lanka descubrió que ciertos tipos de hongos que descomponen árboles de madera dura también pueden degradar algunos polímeros como el polietileno, informa el portal Phys.org.
El trabajo comenzó cuando uno de los científicos notó que varios tipos de hongos son capaces de descomponer árboles de madera dura en una reserva forestal. Se sabe que algunos pueden degradar la lignina, un polímero fuerte presente en la madera.
Biólogos moleculares y de plantas de la Universidad de Kelaniya y la Universidad de Peradeniya probaron en laboratorio 21 especies de hongos que pudren la madera dura, según el estudio publicado en la revista PLOS ONE.
Los expertos determinaron que los hongos pueden descomponer esos compuestos con la ayuda de enzimas. Posteriormente, los autores decidieron probar si también pueden descomponer polímeros artificiales. Para el experimento colocaron láminas de plástico en vasos con hongos, y plástico y madera en otros.
Todos los recipientes se mantuvieron a una temperatura de 28 °C -30 °C durante 45 días. Pasado ese período, se estudió cada uno de los frascos utilizando un método simple con una balanza: cuando los hongos descomponen la madera la lignina se convierte en dióxido de carbono, que se libera al aire, aligerando su peso.
El equipo descubrió que todos los tipos de hongos descompusieron la lámina de plástico. También encontraron que el hongo ‘Phlebiopsis flavidoalba’ superó a las otras especies mostrando el mayor porcentaje de reducción de peso.
El descubrimiento podría sentar una base para nuevos enfoques del uso de hongos para el procesamiento de desechos plásticos.